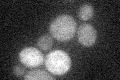
YMR116C
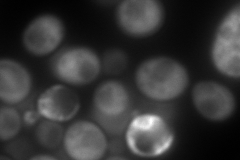
YMR116C
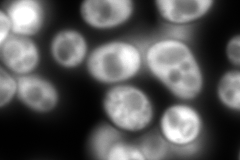
YMR116C

View description
G-protein beta subunit and guanine nucleotide dissociation inhibitor for Gpa2p; ortholog of RACK1 that inhibits translation; core component of the small (40S) ribosomal subunit; represses Gcn4p in the absence of amino acid starvation
Localization:
Intensity:
Fold change:
Significance:
-
C’ GFP library in SD
below threshold17.75 -
N' NOP1pr-GFP in SD

cytosol452.614 -
N' TEF2pr-mCherry in SD
cytosol472.074 -
N' NATIVEpr-GFP in SD
cytosol1720.53 -
N' TEF2pr-VC and Cyto-VN in SD

cytosol90.0517 -
C’ GFP library in SD+DTT

cytosol13.340.75No -
C’ GFP library in SD+H2O2

cytosol17.991.01No -
C’ GFP library in Starvation Media

cytosol16.380.92No -
C’ GFP library on the background of Pup2-DaMP

below threshold -
C’ GFP library on the background of CCT mutant

below threshold21.71921.22273No
